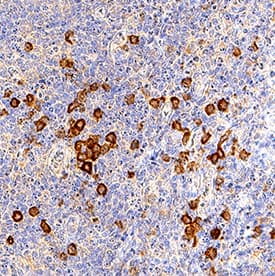
DLEC/CLEC4C/BDCA-2 antibody in Human Tonsil by Immunohistochemistry (IHC-P).

Human DLEC/CLEC4C/BDCA-2 Antibody
R&D Systems, part of Bio-Techne | Catalog # AF1376


Conjugate
Catalog #
Key Product Details
Species Reactivity
Validated:
Human
Cited:
Human, Primate - Macaca mulatta (Rhesus Macaque)
Applications
Validated:
Immunohistochemistry, Western Blot, Flow Cytometry, CyTOF-ready
Cited:
Immunohistochemistry, Immunohistochemistry-Frozen
Label
Unconjugated
Antibody Source
Polyclonal Goat IgG
Product Specifications
Immunogen
Mouse myeloma cell line NS0-derived recombinant human DLEC/CLEC4C/BDCA‑2
Phe46-Ile213
Accession # Q8WTT0
Phe46-Ile213
Accession # Q8WTT0
Specificity
Detects human DLEC/CLEC4C/BDCA‑2 in direct ELISAs and Western blots.
Clonality
Polyclonal
Host
Goat
Isotype
IgG
Scientific Data Images for Human DLEC/CLEC4C/BDCA-2 Antibody
Detection of DLEC/CLEC4C/BDCA‑2 in Human Whole Blood by Flow Cytometry.
Human whole blood were stained with Goat Anti- Human DLEC/CLEC4C/BDCA-2 Antigen Affinity-purified Polyclonal Antibody (Catalog # AF1376) followed by Allophycocyanin-conjugated Anti-Goat IgG Secondary Antibody (Catalog # F0108) and Human IL-3 Ra Phycoerythrin-conjugated Monoclonal Antibody (Catalog # FAB301P).Quadrant markers were set based on control antibody staining (Catalog # AB-108-C).Detection of DLEC/CLEC4C/BDCA‑2 in Human PBMCs by Flow Cytometry.
Human peripheral blood mononuclear cells (PBMCs) were stained with Mouse Anti-Human IL-3 Ra/CD123 APC-conjugated Monoclonal Antibody (Catalog # FAB301A) and either (A) Goat Anti-Human DLEC/CLEC4C/BDCA-2 Antigen Affinity-purified Polyclonal Antibody (Catalog # AF1376) or (B) Normal Goat IgG Control (Catalog # AB-108-C) followed by Allophycocyanin-conjugated Anti-Goat IgG Secondary Antibody (Catalog # F0108).DLEC/CLEC4C/BDCA-2 in Human Lymph Node.
DLEC/CLEC4C/BDCA-2 was detected in immersion fixed paraffin-embedded sections of human lymph node using Goat Anti-Human DLEC/CLEC4C/BDCA-2 Antigen Affinity-purified Polyclonal Antibody (Catalog # AF1376) at 15 µg/mL overnight at 4 °C. Tissue was stained using the Anti-Goat HRP-DAB Cell & Tissue Staining Kit (brown; Catalog # CTS008) and counterstained with hematoxylin (blue). View our protocol for Chromogenic IHC Staining of Paraffin-embedded Tissue Sections.Applications for Human DLEC/CLEC4C/BDCA-2 Antibody
Application
Recommended Usage
CyTOF-ready
Ready to be labeled using established conjugation methods. No BSA or other carrier proteins that could interfere with conjugation.
Flow Cytometry
2.5 µg/106 cells
Sample: Human whole blood and human peripheral blood mononuclear cells (PBMCs)
Sample: Human whole blood and human peripheral blood mononuclear cells (PBMCs)
Immunohistochemistry
5-15 µg/mL
Sample: Immersion fixed paraffin-embedded sections of human lymph node and immersino fixed paraffin-embedded sections of human tonsil
Sample: Immersion fixed paraffin-embedded sections of human lymph node and immersino fixed paraffin-embedded sections of human tonsil
Western Blot
0.1 µg/mL
Sample: Recombinant Human DLEC/CLEC4C/BDCA2 Fc Chimera (Catalog # 1376-DL)
Sample: Recombinant Human DLEC/CLEC4C/BDCA2 Fc Chimera (Catalog # 1376-DL)
Reviewed Applications
Read 2 reviews rated 4.5 using AF1376 in the following applications:
Formulation, Preparation, and Storage
Purification
Antigen Affinity-purified
Reconstitution
Reconstitute at 0.2 mg/mL in sterile PBS. For liquid material, refer to CoA for concentration.
Formulation
Lyophilized from a 0.2 μm filtered solution in PBS with Trehalose. *Small pack size (SP) is supplied either lyophilized or as a 0.2 µm filtered solution in PBS.
Shipping
Lyophilized product is shipped at ambient temperature. Liquid small pack size (-SP) is shipped with polar packs. Upon receipt, store immediately at the temperature recommended below.
Stability & Storage
Use a manual defrost freezer and avoid repeated freeze-thaw cycles.
- 12 months from date of receipt, -20 to -70 °C as supplied.
- 1 month, 2 to 8 °C under sterile conditions after reconstitution.
- 6 months, -20 to -70 °C under sterile conditions after reconstitution.
Background: DLEC/CLEC4C/BDCA-2
References
- Kanazawa, N. et al. (2004) Immunobiology 209:179.
- Arce, I. et al. (2001) Eur. J. Immunol. 31:2733.
- Dzionek, A. et al. (2001) J. Exp. Med. 194:1823.
- Fernandes, M.J. et al. (2000) Genomics 69:263.
- Wu, P. et al. (2008) Clin. Immunol. 129:40.
- Fanning, S.L. et al. (2006) J. Immunol. 177:5829.
- Rock, J. et al. (2007) Eur. J. Immunol. 37:3564.
- Cao, W. et al. (2007) PloS Biol. 5:e248.
- Riboldi, E. et al. (2009) Immunobiology 214:868.
- Martinelli, E. et al. (2007) Proc. Natl. Acad. Sci. USA 104:3396.
- Xu, Y. et al. (2009) Mol. Immunol. 46:2640.
- Jaehn, P.S. et al. (2008) Eur. J. Immunol. 38:1822.
Long Name
Dendritic Cell Lectin
Alternate Names
BDCA-2, BDCA2, CD303, CLEC4C, CLECSF11, CLECSF7
Entrez Gene IDs
170482 (Human)
Gene Symbol
CLEC4C
UniProt
Additional DLEC/CLEC4C/BDCA-2 Products
Product Documents for Human DLEC/CLEC4C/BDCA-2 Antibody
Product Specific Notices for Human DLEC/CLEC4C/BDCA-2 Antibody
For research use only
Loading...
Loading...
Loading...
Loading...
Loading...
Loading...